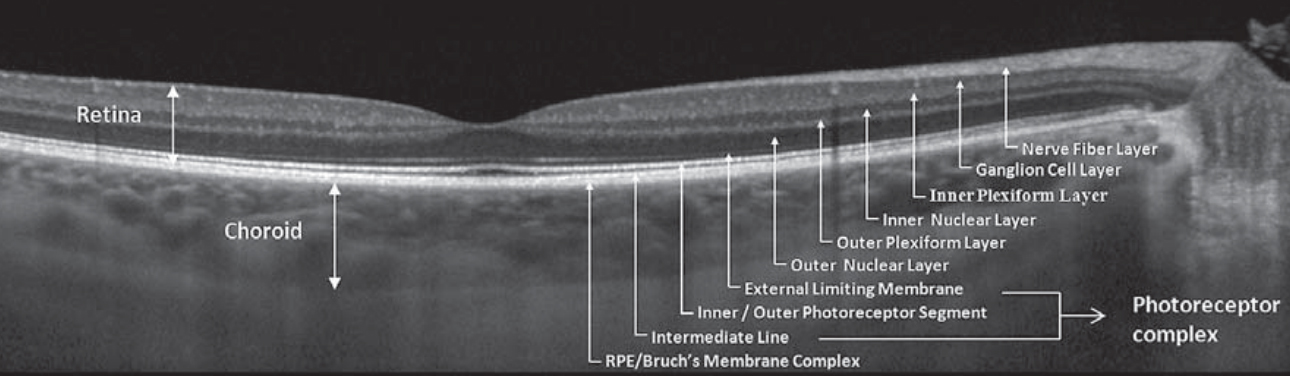

- RETINA
-
- CORNEA
-

- IRIDOCORNEAL ANGLE
-

- CE - corneal epithelium
- ICA - iridocorneal angle
- TM - trabecular meshwork
- SC - scleral spur
- SS - Schlems canala
- IPE - iris pigment epithelium
- SL - sclera
- IS - iris
- OPTIC NERVE


